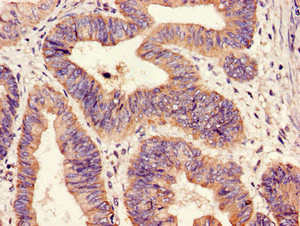

HIPK3 Antibody
-
中文名稱:HIPK3兔多克隆抗體
-
貨號:CSB-PA872492LA01HU
-
規(guī)格:¥440
-
圖片:
-
Immunohistochemistry of paraffin-embedded human bladder cancer using CSB-PA872492LA01HU at dilution of 1:100
-
Immunohistochemistry of paraffin-embedded human colon cancer using CSB-PA872492LA01HU at dilution of 1:100
-
Immunofluorescent analysis of MCF-7 cells using CSB-PA872492LA01HU at dilution of 1:100 and Alexa Fluor 488-congugated AffiniPure Goat Anti-Rabbit IgG(H+L)
-
-
其他:
產(chǎn)品詳情
-
產(chǎn)品名稱:Rabbit anti-Homo sapiens (Human) HIPK3 Polyclonal antibody
-
Uniprot No.:
-
基因名:
-
別名:Androgen receptor interacting nuclear protein kinase antibody; Androgen receptor-interacting nuclear protein kinase antibody; ANPK antibody; DYRK6 antibody; Fas interacting serine/threonine protein kinase antibody; Fas-interacting serine/threonine-protein kinase antibody; FIST antibody; FIST3 antibody; Hipk3 antibody; HIPK3_HUMAN antibody; homeodomain interacting protein kinase 3 antibody; Homeodomain-interacting protein kinase 3 antibody; Homolog of protein kinase YAK1 antibody; PKY antibody; RP24 297H17.5 antibody; YAK1 antibody
-
宿主:Rabbit
-
反應(yīng)種屬:Human
-
免疫原:Recombinant Human Homeodomain-interacting protein kinase 3 protein (841-1130AA)
-
免疫原種屬:Homo sapiens (Human)
-
標(biāo)記方式:Non-conjugated
本頁面中的產(chǎn)品,HIPK3 Antibody (CSB-PA872492LA01HU),的標(biāo)記方式是Non-conjugated。對于HIPK3 Antibody,我們還提供其他標(biāo)記。見下表:
-
克隆類型:Polyclonal
-
抗體亞型:IgG
-
純化方式:>95%, Protein G purified
-
濃度:It differs from different batches. Please contact us to confirm it.
-
保存緩沖液:Preservative: 0.03% Proclin 300
Constituents: 50% Glycerol, 0.01M PBS, pH 7.4 -
產(chǎn)品提供形式:Liquid
-
應(yīng)用范圍:ELISA, IHC, IF
-
推薦稀釋比:
Application Recommended Dilution IHC 1:20-1:200 IF 1:50-1:200 -
Protocols:
-
儲存條件:Upon receipt, store at -20°C or -80°C. Avoid repeated freeze.
-
貨期:Basically, we can dispatch the products out in 1-3 working days after receiving your orders. Delivery time maybe differs from different purchasing way or location, please kindly consult your local distributors for specific delivery time.
-
用途:For Research Use Only. Not for use in diagnostic or therapeutic procedures.
相關(guān)產(chǎn)品
靶點詳情
-
功能:Serine/threonine-protein kinase involved in transcription regulation, apoptosis and steroidogenic gene expression. Phosphorylates JUN and RUNX2. Seems to negatively regulate apoptosis by promoting FADD phosphorylation. Enhances androgen receptor-mediated transcription. May act as a transcriptional corepressor for NK homeodomain transcription factors. The phosphorylation of NR5A1 activates SF1 leading to increased steroidogenic gene expression upon cAMP signaling pathway stimulation. In osteoblasts, supports transcription activation: phosphorylates RUNX2 that synergizes with SPEN/MINT to enhance FGFR2-mediated activation of the osteocalcin FGF-responsive element (OCFRE).
-
基因功能參考文獻(xiàn):
- HIPK1, HIPK2 and HIPK3 interact with the components of the carbon catabolite repressor 4 (CCR4)-negative on TATA (NOT) complex, an important regulator of all the major steps in the mRNA metabolism. it has emerged that HIPKs and their related miRNAs are involved in diabetic nephropathy, gastric cancer chemoresistance, cervical cancer progression, and recombinant protein expression in cultured cells. [Review] PMID: 29793420
- Overexpression of circHIPK3 promoted NCI-H1299 cell proliferation and knock-down of circHIPK3 inhibited cell proliferation. PMID: 28738961
- The two kinases HIPK3 and MAPK11 effect on Huntingtin (HTT)levels are mutant HTT protein (mHTT)-dependent, providing a feedback mechanism in which mHTT enhances its own level thus contributing to mHTT accumulation and disease progression. PMID: 29151587
- Over-expression of circHIPK3 effectively inhibits migration, invasion, and angiogenesis of bladder cancer cells in vitro and suppresses bladder cancer growth and metastasis in vivo Mechanistic studies reveal that circHIPK3 contains two critical binding sites for the microRNA miR-558 and can abundantly sponge miR-558 to suppress the expression of heparanase (HPSE). PMID: 28794202
- circHIPK3 directly binds to miR-124 and inhibits miR-124 activity and cell cycle progression. PMID: 27050392
- Analysis of these mutants revealed that HIPK1, HIPK2 and HIPK3 but not HIPK4 are capable of autophosphorylating on other tyrosines PMID: 25630557
- JNK regulates the expression of HIPK3 in prostate cancer cells, which leads to increased resistance to Fas receptor-mediated apoptosis by reducing the interaction between FADD and caspase-8 PMID: 14766760
- This finding has linked three common factors, HIPK3, JNK, and c-Jun, to the cAMP signaling pathway leading to increased steroidogenic gene expression PMID: 17210646
顯示更多
收起更多
-
亞細(xì)胞定位:Cytoplasm. Nucleus.
-
蛋白家族:Protein kinase superfamily, CMGC Ser/Thr protein kinase family, HIPK subfamily
-
組織特異性:Overexpressed in multidrug resistant cells. Highly expressed in heart and skeletal muscle, and at lower levels in placenta, pancreas, brain, spleen, prostate, thymus, testis, small intestine, colon and leukocytes. Not found in liver and lung.
-
數(shù)據(jù)庫鏈接:
Most popular with customers
-
YWHAB Recombinant Monoclonal Antibody
Applications: ELISA, WB, IHC, IF, FC
Species Reactivity: Human, Mouse, Rat
-
Phospho-YAP1 (S127) Recombinant Monoclonal Antibody
Applications: ELISA, WB, IHC
Species Reactivity: Human
-
-
-
-
-
-